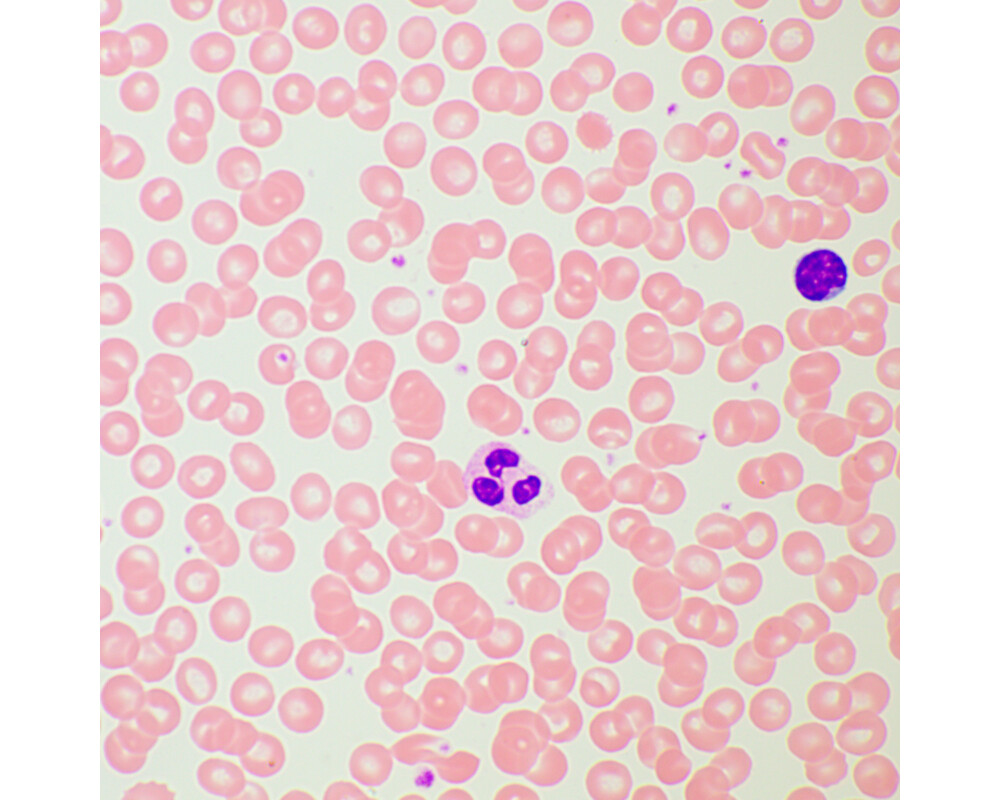

- Начало
- Оптични уреди и измервателни инструменти
- Микроскопи
- Magus
- Биологичен MAGUS Bio 260T (ID: 722944)
Микроскоп Биологичен MAGUS Bio 260T 83479
кодирана револверна глава, ахроматични обективи, светодиоден илюминатор на светлина 3 W, интелигентна система за управление на осветлението
Гаранция:
0.0
от 5.0
(0)
Купи и събери
20 точки
Плати по-лесно и сигурно с
ID: 722944
Характеристики
| Тип | биологичен, светлина/оптичен |
| Подходящо за | лабораторно/медицинско |
| Употреба | за професионалисти, опитни потребители |
| Монтаж и инсталиране | сложен |
| Technique | на светлото поле |
| Head | глава Gemel (Siedentopf, завъртане на 360°), с разпределение 50/50 на светлинния поток |
| Head angle | 30 ° |
| Revolver | 5 обектива, кодирани |
| Увеличение, x | 40 — 1000 x |
| Окуляри |
10x/22
голямо разстояние от очите (*опция: 10x/22 със скала 10x/22 с решетка 10x/22 с мерник 12,5x/17,5 15x/16 20x/12) |
| Диаметър на окуляра | 30 мм. |
| Диоптрична корекция на окуляра | ± 5D на всеки от окулярите |
| Фокусиране | коаксиално, грубо (30 mm, 37,7 mm/кръг с механизъм за регулиране на напрежението) и фино (0,002 mm, 0,2 mm/кръг) |
| Diaphragm | диафрагма с регулируема апертура, полева диафрагма с регулируем ирис |
| Objectives | планахроматични, коригирани до безкрайност: 4x/0,10; 10x/0,25; 40x/0,65; 100xs/1,25 маслени (*опция: 20x/0,40); парфокална височина 60 mm |
| Филтри | да |
| Working distance | 30 (4x); 10,2 (10x); 1,5 (40x); 0,2 (100xs) mm |
| Разстояние между окулярите (IPD), mm | 47 — 78 мм. |
| Condenser | кондензер на Abbe с цифрова апертура 1,25, с възможност за центриране и регулиране на височината, с регулируема диафрагма на апертурата, слот с букса за плъзгачи за метода на тъмното поле или за фазов контраст; монтировка тип „лястовича опашка“ |
| Light source type | светодиодно |
| Light source | светодиод 3 W |
| Light source placement | долно |
| Brightness control |
|
| Работна температура | 0 — 70 °С |
| Expansion |
илюминатор за отразена светлина
плъзгач за метода на тъмното поле устройства за поляризация (поляризатор и анализатор) фазовоконтрастно устройство (плъзгач и обективи) кондензер за метода на тъмното поле в имерсионно масло (сух или в масло) фазовоконтрастно устройство (кондензер и обективи) |
| Stage | 230x150 мм. |
| Stage adjustment | 78/54 |
| Stage features | двуосова механична предметна маса, без рейка за позициониране |
| Размери на продукта | 47x32x67 cm см. |
| Захранване | 100–240 V, 50/60 Hz, променливотокова мрежа |
| Тегло | 12.2 kg кг. |
| Други характеристики | автоматично регулиране на яркостта при превключване на обективите, екран с течнокристален дисплей за състоянието, режим „еко“, „спящ“ режим |
| Гаранция | 24 месеца |
| Код на продукта | 83479 |
Виж повече
Допълнителна информация
<p>Микроскопът е подходящ за наблюдение на прозрачни и полупрозрачни биологични проби, като натривки и напречни сечения, по метода на светлото поле с преминаваща светлина. Монтирането на допълнителни принадлежности ще осигури възможност за използване на методите на тъмното поле, фазовия контраст, флуоресценцията и поляризацията.
Кодираната револверна глава поддържа удобно за наблюдение ниво на яркостта при превключване на обективите. Интелигентното управление на осветлението на микроскопа увеличава комфорта и скоростта на рутинната работа на научния работник. “Интелигентните” функции помагат на студентите за по-лесно навлизане в професията и придобиване на необходимия професионален опит.<br />
Микроскопът е подходящ за лабораторна работа, изследвания и обучение.</p>
<p><strong>Глава на микроскопа</strong></p>
<p>Тринокулярна глава с коригирана до безкрайност оптика. Окулярните тръби могат да се въртят на 360°. Потребителят може да регулира разстоянието от очите на окулярите, за да отговаря на неговия ръст. В тринокулярната тръба е монтирана цифрова камера. Разделянето на лъчите е 50/50.<br />
Основният комплект включва окуляри 10x/22 mm с регулиране на диоптъра и голямо разстояние от очите за работа с очила. Плоски гумени чашки за очите предпазват оптиката от надрасквания.</p>
<p><strong>Револверна глава и обективи</strong></p>
<p>Кодираната револверна глава за 5 обектива е ориентирана навътре: потребителят може да вижда поставения в оптичния път обектив, а пространството над предметната маса е свободно. В свободния слот може да бъде монтиран допълнителен обектив, за да се постигне още по-голямо увеличение. Парфокалното разстояние е 60 mm.
Над револвера се намира слот с букса за инсталиране на анализатора.</p>
<p><strong>Поддържане на комфортни нива на яркост при превключване на увеличенията</strong></p>
<p>Обективите с различни увеличения предават светлината с различни нива на интензитет и затова всеки път, когато сменяте обективите, яркостта на светлината трябва да се регулира. В допълнение яркостта се повишава рязко при промяна от обектив с по-голямо увеличение към обектив с по-малко увеличение. Рязкото увеличаване на яркостта уморява очите. MAGUS Bio 260T е оборудван с интелигентен контрол на яркостта. Микроскопът запаметява яркостта за всеки избран от потребителя обектив и задава автоматично съответната яркост при завъртане на револверната глава. Интелигентното управление намалява необходимото време за регулиране на яркостта. MAGUS Bio 260T повишава комфорта за потребителя и спестява време, дори когато работата изисква чести промени в увеличението.</p>
<p><strong>Фокусиращ механизъм</strong></p>
<p>Коаксиални бутони за грубо и фино фокусиране.<br />
Бутонът за грубо фокусиране се намира от лявата страна. Бутоните за фино фокусиране се намират и от двете страни; десният бутон има вдлъбнатини за пръстите.<br />
Бутонът за застопоряване при грубо фокусиране Ви предоставя възможност за бързо регулиране на микроскопа след смяна на обекта на изследването. Бутонът се намира от лявата страна на микроскопа на оста на механизма за фокусиране.<br />
Пръстенът от дясната страна регулира усилието при грубото фокусиране. Потребителят настройва удобното за работа усилие.</p>
<p><strong>Предметна маса</strong></p>
<p>За осигуряване на ергономична работа с работната маса тя няма рейка за позициониране по оста X. Задвижваният с ремък механизъм осигурява възможност за плавно преместване на образеца. Държачът за образеца е закрепен с два винта и може да се отстранява лесно по време на ръчно сканиране.<br />
Дългата ръкохватка за контрол на предметната маса осигурява комфорт по време на работа: ръката лежи върху масата без напрежение.</p>
<p><strong>Кондензер</strong></p>
<p>Кондензерът може да се настройва по височина и да се центрира. Тип монтировка: лястовича опашка.<br />
Пръстенът на кондензера регулира диафрагмата на ирисната апертура. Тялото на кондензера има маркировка за увеличенията на обективите, а пръстенът има и указателна маркировка. За да постигнете контраст при всеки обектив, се препоръчва да завъртате пръстена така, че указателната маркировка да съвпада с маркировката на увеличението на използвания обектив.<br />
Кондензерът има слот с букса за плъзгач за метода на тъмното поле или плъзгач за фазов контраст. Монтажът на плъзгач пести време при смяна на метода на наблюдение.</p>
<p><strong>Осветление</strong></p>
<p>Илюминаторът за преминаваща светлина има светодиод 3 W. Цветната температура не се променя при регулиране на яркостта. Животът на светодиода е 50 000 часа.</p>
<p><strong>Осветление на Кьолер с преминаваща светлина</strong></p>
<p>Осветлението на Кьолер подобрява качеството на изображението на наблюдавания образец: всеки обектив постига максимална разделителна способност и зрителното поле се осветява равномерно без затъмняване в краищата. Обектът на изследване е с отчетлив фокус и са премахнати смущенията в изображението.</p>
<p><strong>Екран с течнокристален дисплей за състоянието</strong></p>
<p>Течнокристалният екран в основата на микроскопа показва увеличението на обектива, яркостта и цветовата температура на светлинния източник, както и режима на работа („спящ“ и „еко“).<br />
Потребителят на микроскопа регулира яркостта, фиксира регулирането на яркостта и настройва спящия режим и таймера за автоматично изключване, като използва екрана и двата бутона.</p>
<p><strong>Ергономична конструкция</strong></p>
<p>Физическото неудобство води до умора и намалява продуктивността. Ергономичната конструкция на микроскопа играе важна роля в ежедневните научни проучвания.<br />
MAGUS Bio 260T предлага удобство на потребителя по време на работа.<br />
Чрез завъртане на главата на микроскопа потребителят избира височина на гледната точка така, че да не напряга гърба и врата си.<br />
Бутоните за фокусиране се намират в долната част на тялото. Потребителят не напряга ръцете си. Благодарение на плавното движение на механизма потребителят може без усилие да фокусира върху обекта.<br />
Микроскопът работи с минимално движение на ръцете, тъй като дългата ръкохватка за контрол на предметната маса и бутонът за фино фокусиране са разположени в същата работна зона.<br />
Микроскопът е оборудван със специална дръжка за пренасяне.<br />
Конструкцията за скрито разположение на захранващия кабел подобрява естетиката на работното място и безопасността при пренасяне на микроскопа, както и улеснява съхранението на устройството.</p>
<p><strong>Принадлежности</strong></p>
<p>Има набор от принадлежности, конструирани за този микроскоп.<br />
Допълнителните обективи осигуряват допълнително увеличение.<br />
Окулярите разширяват диапазона на увеличение на микроскопа. Допълнителни окуляри Ви помагат да увеличите максимално потенциала на обектива, който използвате най-често.<br />
Фазовоконтрастното устройство, кондензерът за тъмното поле и устройството за поляризация предлагат повече контрастни техники, за да изучавате образците, които са невидими при метода на светлото поле.<br />
Цифрова камера пренася изображението от микроскопа на монитор, запаметява файлове, а софтуер прави измервания на образци в реално време.<br />
За измерване на обекти се използват калибрационен образец, който може да се комбинира с окуляр със скала или със софтуера на камерата.</p>
<p><strong>Основни характеристики:</strong></p>
<ul>
<li>Наблюдение на прозрачни и полупрозрачни образци по метода на светлото поле с пропусната светлина</li>
<li>Тринокулярната глава с вертикална тръба за монтиране на цифрова камера и регулируема височина за регулиране спрямо наблюдаващия; разделяне на светлинния лъч 50/50</li>
<li>Кодирана револверна глава: яркостта на източника на светлина се задава автоматично в зависимост от избрания обектив</li>
<li>Илюминаторът за преминаваща светлина е енергоспестяващ светодиод 3 W със срок на експлоатация до 50 000 часа</li>
<li>Осветление на Кьолер за преминаваща светлина, центриран кондензер с регулируема височина и маркировка за увеличението на обектива</li>
<li>Интелигентна система за контрол на осветлението: автоматичен избор на яркостта, фиксатор на затъмняването, таймер за автоматично изключване, течнокристален дисплей за състоянието на работата</li>
<li>Предметна маса без позиционираща рейка по оста X и с дълга ръкохватка за контрол за удобна работа</li>
<li>Ергономична стойка с дръжка за пренасяне и скрито разположение на захранващия кабел </li>
<li>Широка гама съвместими допълнителни принадлежности</li>
</ul>
<p><strong>Комплектът включва:</strong></p>
<ul>
<li>Стойка с вградено захранване, светлинен източник за преминаваща светлина, фокусиращ механизъм, предметна маса, монтировка за кондензер и револверна глава</li>
<li>Кондензер Abbe</li>
<li>Тринокулярна глава</li>
<li>Коригиран до безкрайност планахроматичен обектив: 4x/0,10, парфокална височина 60 mm</li>
<li>Коригиран до безкрайност планахроматичен обектив: 10x/0,25, парфокална височина 60 mm</li>
<li>Коригиран до безкрайност планахроматичен обектив: 40x/0,65 (пружинно натоварен), парфокална височина 60 mm</li>
<li>Коригиран до безкрайност планахроматичен обектив: 100x/0,25 маслен (пружинно натоварен), парфокална височина 60 mm</li>
<li>Окуляр 10x/22 mm с голямо разстоянието от очите и регулиране на диоптъра (2 бр.)</li>
<li>Чашка за окуляр (2 бр.)</li>
<li>Светлинен филтър</li>
<li>Адаптер за камера с С-образна монтировка</li>
<li>Бутилка с имерсионно масло</li>
<li>Променливотоков захранващ кабел</li>
<li>Покривало против прах </li>
<li>Ръководство за потребителя и гаранционна карта</li>
</ul>
<p><strong>Предлагат се по заявка:</strong></p>
<ul>
<li>Окуляр 10x/22 mm със скала</li>
<li>Окуляр 10x/22 mm с решетка</li>
<li>Окуляр 10x/22 mm с мерник</li>
<li>Окуляр 12,5x/17,5 mm (2 бр.)</li>
<li>Окуляр 15x/16 mm (2 бр.)</li>
<li>Окуляр 20x/12 mm (2 бр.)</li>
<li>Коригиран до безкрайност планахроматичен обектив: 20x/0,40, парфокална височина 60 mm</li>
<li>Фазовоконтрастно устройство: комплект от фазови плъзгачи, допълнителен центриращ телескоп, комплект от фазови обективи</li>
<li>Плъзгач за метода на тъмното поле</li>
<li>Илюминатор за отразена светлина</li>
<li>Устройство за поляризация</li>
<li>Цифрова камера</li>
<li>Калибрационен образец</li>
<li>Монитор</li>
</ul>
Виж повече
Допълнителна информация
Виж повече
Информация за производителя
| Контакт | [email protected] |
| Адрес | ул. Акад. Стефан Младенов 46, София, 1700, България |
| Уебсайт | https://magusmicro.bg/ |
Виж повече
Ние от PIC.bg постоянно полагаме усилия информацията на тази страница да е точна. В редки случаи съдържанието може да е некоректно. Всички снимки са с информативна цел и е възможно да съдържат аксесоари, които не са включени в стандартния пакет. Някои от спецификациите или цените могат да бъдат променяни от производителя без предизвестие или да съдържат експлоатационни грешки. Всички промоции, посочени в сайта, се предлагат до изчерпаване на количествата.
Отзиви
0.0
0 отзива.
5
0
4
0
3
0
2
0
1
0
Оцени продукта
Добави отзив